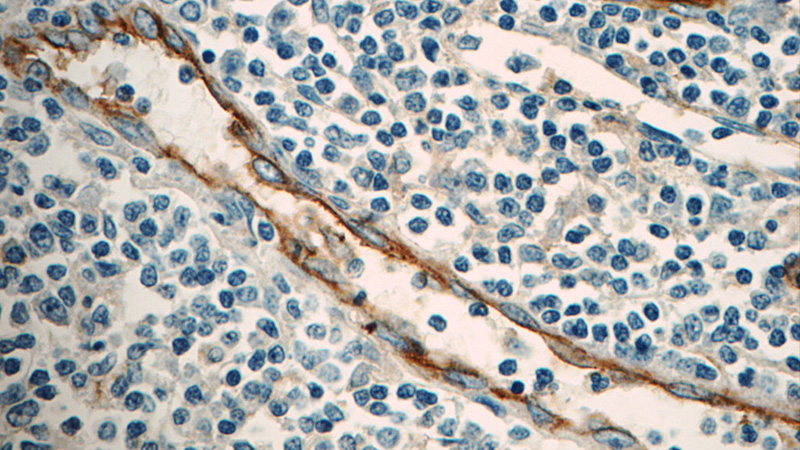
Immunohistochemistry of paraffin-embedded human tonsillitis tissue slide using Catalog No:107272(ICAM-1 Antibody) at dilution of 1:50 (under 40x lens)

-
Product Name
ICAM-1 antibody
- Documents
-
Description
ICAM-1 Mouse Monoclonal antibody. Positive WB detected in Raji cells, HeLa cells. Positive IHC detected in human tonsillitis tissue. Positive FC detected in Raji cells. Observed molecular weight by Western-blot: 85-95 kDa
-
Tested applications
ELISA, IHC, FC, WB
-
Species reactivity
Human; other species not tested.
-
Alternative names
BB2 antibody; CD54 antibody; ICAM 1 antibody; ICAM1 antibody; ICAM-1 antibody; P3.58 antibody
-
Isotype
Mouse IgG2b
-
Preparation
This antibody was obtained by immunization of ICAM-1 recombinant protein (Accession Number: NM_000201). Purification method: Protein A purified.
-
Clonality
Monoclonal
-
Formulation
PBS with 0.02% sodium azide and 50% glycerol pH 7.3.
-
Storage instructions
Store at -20℃. DO NOT ALIQUOT
-
Applications
Recommended Dilution:
WB: 1:1000-1:10000
IHC: 1:20-1:200
-
Validations

Raji cells were subjected to SDS PAGE followed by western blot with Catalog No:107272(ICAM-1 Antibody) at dilution of 1:2000

Immunohistochemistry of paraffin-embedded human tonsillitis tissue slide using Catalog No:107272(ICAM-1 Antibody) at dilution of 1:50 (under 10x lens)
Immunohistochemistry of paraffin-embedded human tonsillitis tissue slide using Catalog No:107272(ICAM-1 Antibody) at dilution of 1:50 (under 40x lens)

1X10^6 Raji cells were stained with 0.2ug ICAM-1 antibody (Catalog No:107272, red) and control antibody (blue). Fixed with 90% MeOH blocked with 3% BSA (30 min). Alexa Fluor 488-congugated AffiniPure Goat Anti-Mouse IgG(H+L) with dilution 1:1000.
-
Background
ICAM-1 (CD54) is a 90-kDa transmembrane glycoprotein of the immunoglobulin superfamily and is critical for the firm attachment and transmigration of leukocytes out of blood vessels and into tissues (PMID: 19307690). ICAM-1 is expressed by several cell types, typically on endothelial cells and cells of the immune system, and its expression can be up-regulated by various stimuli, including TNF-α, INF-γ, IL-1 and thrombin (PMID: 3086451; 9694714; 15979056). It is a ligand for LFA-1 and Mac-1, serves as a receptor for rhinovirus, and is one of several receptors used by Plasmodium falciparum (PMID: 2566624; 2538244; 2475784).
-
References
- Kawasaki K, Muroyama K, Yamamoto N, Murosaki S. A hot water extract of Curcuma longa inhibits adhesion molecule protein expression and monocyte adhesion to TNF-α-stimulated human endothelial cells. Bioscience, biotechnology, and biochemistry. 79(10):1654-9. 2015.
- Liu H, Tang J, Du Y. Retinylamine Benefits Early Diabetic Retinopathy in Mice. The Journal of biological chemistry. 290(35):21568-79. 2015.
- Di-Cicco A, Petit V, Chiche A. Paracrine Met signaling triggers epithelial-mesenchymal transition in mammary luminal progenitors, affecting their fate. eLife. 4:. 2015.
- Liu Y, Yang G, Zhang J. Anti-TNF-α monoclonal antibody reverses psoriasis through dual inhibition of inflammation and angiogenesis. International immunopharmacology. 28(1):731-43. 2015.
- Xu B, Yang H, Sun M. 2,3',4,4',5-Pentachlorobiphenyl Induces Inflammatory Responses in the Thyroid Through JNK and Aryl Hydrocarbon Receptor-Mediated Pathway. Toxicological sciences : an official journal of the Society of Toxicology. 149(2):300-11. 2016.
Related Products / Services
Please note: All products are "FOR RESEARCH USE ONLY AND ARE NOT INTENDED FOR DIAGNOSTIC OR THERAPEUTIC USE"
